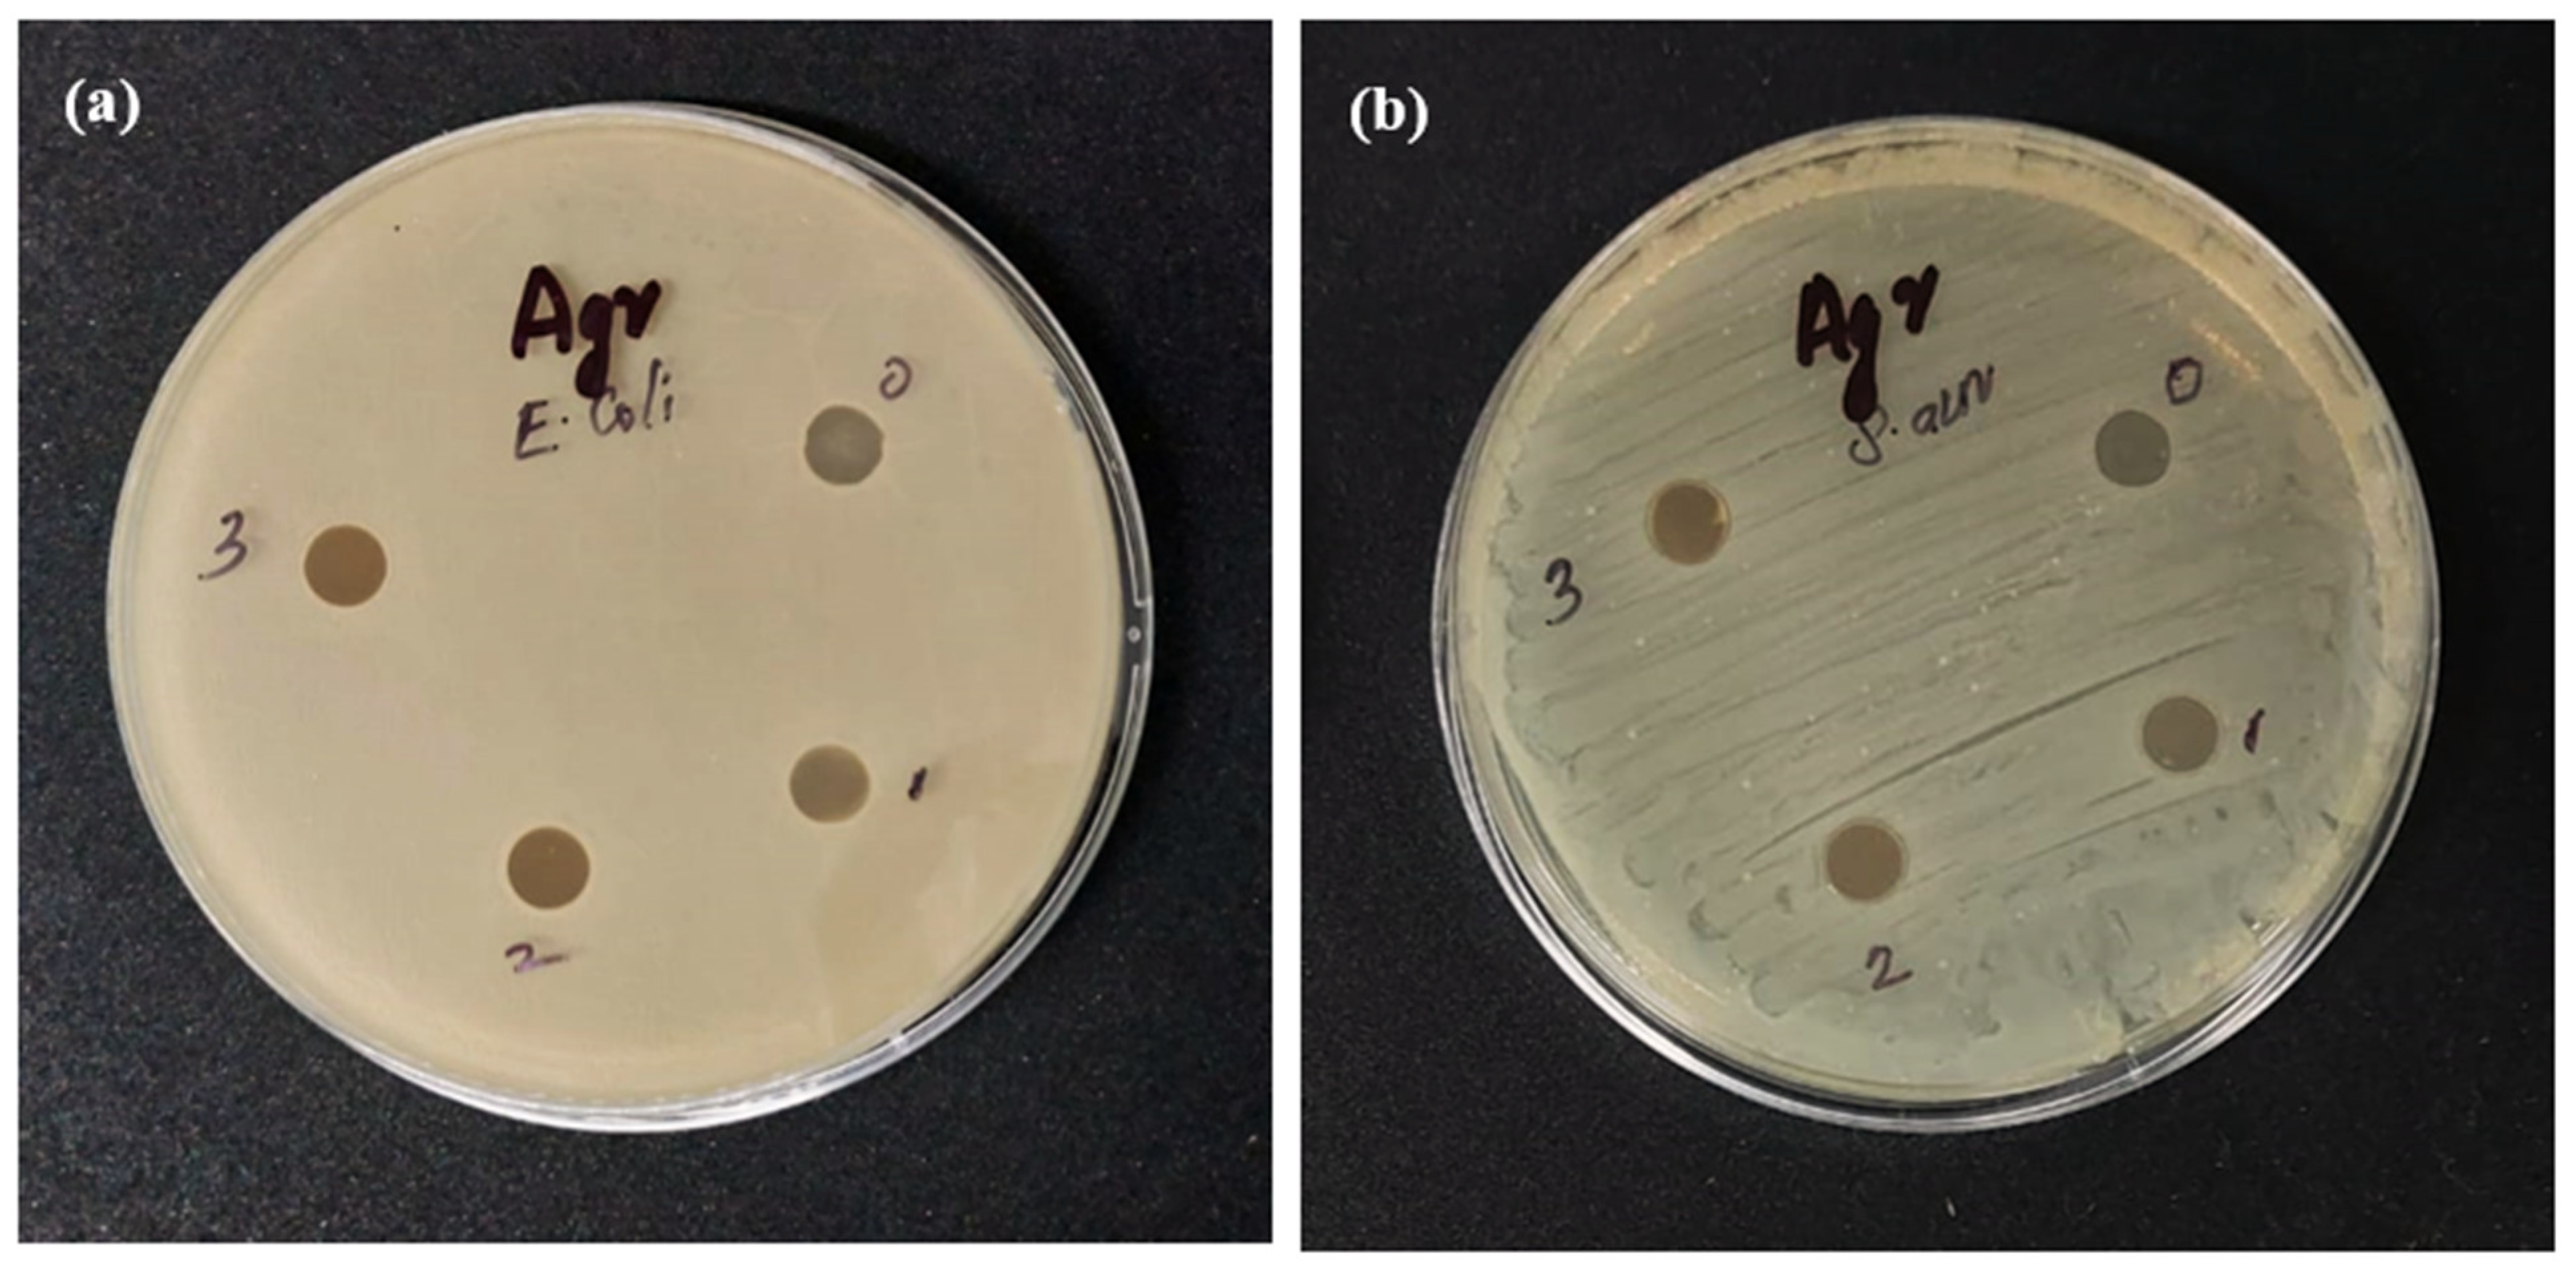
Catalysts 12 00886 g008

Efficient Removal of Organic Dye from Aqueous Solution Using Hierarchical Zeolite-Based Biomembrane: Isotherm, Kinetics, Thermodynamics and Recycling Studies
Abstract
:1. Introduction
2. Materials and Methods
2.1. Materials
2.2. Methods
2.2.1. Surfactant Templated ZSM-5 Zeolite Synthesis
2.2.2. Preparation of Agar/Zeolite/CMC/PVA Biomembrane
2.3. Characterisation
2.4. Adsorption Experiments
2.5. Desorption Procedure
3. Result and Discussions
3.1. Characterisation of Agar/Zeolite/CMC/PVA Biomembrane
3.2. Congo Red Removal Performance of Agar/Zeolite/CMC/PVA Biomembrane
3.3. Thermodynamics
3.4. Adsorption Kinetics
3.5. Isothermal Studies
Scheme of Dye Adsorption
3.6. Reusability and Regeneration Studies
3.7. Comparison of Agar/Zeolite/CMC/PVA Biomembrane with Other Adsorbents for CR Adsorption
4. Conclusions
Supplementary Materials
Author Contributions
Funding
Data Availability Statement
Acknowledgments
Conflicts of Interest
References
- Qiao, A.; Cui, M.; Huang, R.; Ding, G.; Qi, W.; He, Z.; Klemeš, J.J.; Su, R. Advances in nanocellulose-based materials as adsorbents of heavy metals and dyes. Carbohydr. Polym. 2021, 272, 118471. [Google Scholar] [CrossRef]
- Abou-Zeid, R.E.; Khiari, R.; El-Wakil, N.; Dufresne, A. Current State and New Trends in the Use of Cellulose Nanomaterials for Wastewater Treatment. Biomacromolecules 2018, 20, 573–597. [Google Scholar] [CrossRef] [PubMed]
- Batmaz, R.; Mohammed, N.; Zaman, M.; Minhas, G.; Berry, R.M.; Tam, K.C. Cellulose nanocrystals as promising adsorbents for the removal of cationic dyes. Cellulose 2014, 21, 1655–1665. [Google Scholar] [CrossRef]
- Palma, P.; Alvarenga, P.; Palma, V.L.; Fernandes, R.M.; Soares, A.; Barbosa, I. Assessment of anthropogenic sources of water pollution using multivariate statistical techniques: A case study of the Alqueva’s reservoir, Portugal. Environ. Monit. Assess. 2009, 165, 539–552. [Google Scholar] [CrossRef] [PubMed]
- Lee, J.; Chae, H.-R.; Won, Y.J.; Lee, K.; Lee, C.-H.; Lee, H.H.; Kim, I.-C.; Lee, J.-M. Graphene oxide nanoplatelets composite membrane with hydrophilic and antifouling properties for wastewater treatment. J. Membr. Sci. 2013, 448, 223–230. [Google Scholar] [CrossRef]
- Manna, S.; Das, P.; Basak, P.; Sharma, A.K.; Singh, V.K.; Patel, R.K.; Pandey, J.K.; Ashokkumar, V.; Pugazhendhi, A. Separation of pollutants from aqueous solution using nanoclay and its nanocomposites: A review. Chemosphere 2021, 280, 130961. [Google Scholar] [CrossRef] [PubMed]
- Radoor, S.; Karayil, J.; Jayakumar, A.; Parameswaranpillai, J.; Siengchin, S. Efficient removal of methyl orange from aqueous solution using mesoporous ZSM-5 zeolite: Synthesis, kinetics and isotherm studies. Colloids Surfaces A Physicochem. Eng. Asp. 2020, 611, 125852. [Google Scholar] [CrossRef]
- Waheed, A.; Baig, N.; Ullah, N.; Falath, W. Removal of hazardous dyes, toxic metal ions and organic pollutants from wastewater by using porous hyper-cross-linked polymeric materials: A review of recent advances. J. Environ. Manag. 2021, 287, 112360. [Google Scholar] [CrossRef]
- Srivastava, A.; Rani, R.M.; Patle, D.S.; Kumar, S. Emerging bioremediation technologies for the treatment of textile wastewater containing synthetic dyes: A comprehensive review. J. Chem. Technol. Biotechnol. 2021, 97, 26–41. [Google Scholar] [CrossRef]
- Kim, I.; Choi, D.-C.; Lee, J.; Chae, H.-R.; Jang, J.H.; Lee, C.-H.; Park, P.-K.; Won, Y.-J. Preparation and application of patterned hollow-fiber membranes to membrane bioreactor for wastewater treatment. J. Membr. Sci. 2015, 490, 190–196. [Google Scholar] [CrossRef]
- Bilal, M.; Ihsanullah, I.; Younas, M.; Shah, M.U.H. Recent advances in applications of low-cost adsorbents for the removal of heavy metals from water: A critical review. Sep. Purif. Technol. 2021, 278, 119510. [Google Scholar] [CrossRef]
- Gahlot, R.; Taki, K.; Kumar, M. Efficacy of nanoclays as the potential adsorbent for dyes and metal removal from the wastewater: A review. Environ. Nanotechnol. Monit. Manag. 2020, 14, 100339. [Google Scholar] [CrossRef]
- Sabarish, R.; Unnikrishnan, G. Polyvinyl alcohol/carboxymethyl cellulose/ZSM-5 zeolite biocomposite membranes for dye adsorption applications. Carbohydr. Polym. 2018, 199, 129–140. [Google Scholar] [CrossRef] [PubMed]
- Liu, J.; Chen, T.-W.; Yang, Y.-L.; Bai, Z.-C.; Xia, L.-R.; Wang, M.; Lv, X.-L.; Li, L. Removal of heavy metal ions and anionic dyes from aqueous solutions using amide-functionalized cellulose-based adsorbents. Carbohydr. Polym. 2020, 230, 115619. [Google Scholar] [CrossRef] [PubMed]
- Ren, L.; Zhou, D.; Wang, J.; Zhang, T.; Peng, Y.; Chen, G. Biomaterial-based flower-like MnO2@ carbon microspheres for rapid adsorption of amoxicillin from wastewater. J. Mol. Liq. 2020, 309, 113074. [Google Scholar] [CrossRef]
- Siyal, A.A.; Shamsuddin, M.R.; Low, A.; Rabat, N.E. A review on recent developments in the adsorption of surfactants from wastewater. J. Environ. Manag. 2019, 254, 109797. [Google Scholar] [CrossRef]
- Mustafa, R.; Asmatulu, E. Preparation of activated carbon using fruit, paper and clothing wastes for wastewater treatment. J. Water Process Eng. 2020, 35, 101239. [Google Scholar] [CrossRef]
- Svetozarević, M.; Šekuljica, N.; Knežević-Jugović, Z.; Mijin, D. Agricultural waste as a source of peroxidase for wastewater treatment: Insight in kinetics and process parameters optimization for anthraquinone dye removal. Environ. Technol. Innov. 2020, 21, 101289. [Google Scholar] [CrossRef]
- Mahouachi, L.; Rastogi, T.; Palm, W.-U.; Ghorbel-Abid, I.; Chehimi, D.B.H.; Kümmerer, K. Natural clay as a sorbent to remove pharmaceutical micropollutants from wastewater. Chemosphere 2020, 258, 127213. [Google Scholar] [CrossRef] [PubMed]
- Radoor, S.; Karayil, J.; Parameswaranpillai, J.; Siengchin, S. Removal of anionic dye Congo red from aqueous environment using polyvinyl alcohol/sodium alginate/ZSM-5 zeolite membrane. Sci. Rep. 2020, 10, 15452. [Google Scholar] [CrossRef]
- Radoor, S.; Karayil, J.; Parameswaranpillai, J.; Siengchin, S. Adsorption of methylene blue dye from aqueous solution by a novel PVA/CMC/halloysite nanoclay bio composite: Characterization, kinetics, isotherm and antibacterial properties. J. Environ. Heal. Sci. Eng. 2020, 18, 1311–1327. [Google Scholar] [CrossRef] [PubMed]
- Sabarish, R.; Unnikrishnan, G. PVA/PDADMAC/ZSM-5 zeolite hybrid matrix membranes for dye adsorption: Fabrication, characterization, adsorption, kinetics and antimicrobial properties. J. Environ. Chem. Eng. 2018, 6, 3860–3873. [Google Scholar] [CrossRef]
- Zhang, C.-J.; Hu, M.; Ke, Q.-F.; Guo, C.-X.; Guo, Y.-J. Nacre-inspired hydroxyapatite/chitosan layered composites effectively remove lead ions in continuous-flow wastewater. J. Hazard. Mater. 2019, 386, 121999. [Google Scholar] [CrossRef] [PubMed]
- McLeary, E.; Jansen, J.; Kapteijn, F. Zeolite based films, membranes and membrane reactors: Progress and prospects. Microporous Mesoporous Mater. 2006, 90, 198–220. [Google Scholar] [CrossRef]
- Sabarish, R.; Unnikrishnan, G. Synthesis, characterization and evaluations of micro/mesoporous ZSM-5 zeolite using starch as bio template. SN Appl. Sci. 2019, 1, 989. [Google Scholar] [CrossRef]
- Radoor, S.; Karayil, J.; Jayakumar, A.; Parameswaranpillai, J.; Siengchin, S. Removal of Methylene Blue Dye from Aqueous Solution using PDADMAC Modified ZSM-5 Zeolite as a Novel Adsorbent. J. Polym. Environ. 2021, 29, 3185–3198. [Google Scholar] [CrossRef]
- Radoor, S.; Karayil, J.; Jayakumar, A.; Parameswaranpillai, J.; Siengchin, S. An efficient removal of malachite green dye from aqueous environment using ZSM-5 zeolite/polyvinyl alcohol/carboxymethyl cellulose/sodium alginate bio composite. J. Polym. Environ. 2021, 29, 2126–2139. [Google Scholar] [CrossRef]
- Hong, M.; Yu, L.; Wang, Y.; Zhang, J.; Chen, Z.; Dong, L.; Zan, Q.; Li, R. Heavy metal adsorption with zeolites: The role of hierarchical pore architecture. Chem. Eng. J. 2018, 359, 363–372. [Google Scholar] [CrossRef]
- Dong, T.; Liu, W.; Ma, M.; Peng, H.; Yang, S.; Tao, J.; He, C.; Wang, C.; Wu, P.; An, T. Hierarchical zeolite enveloping Pd-CeO2 nanowires: An efficient adsorption/catalysis bifunctional catalyst for low temperature propane total degradation. Chem. Eng. J. 2020, 393, 124717. [Google Scholar] [CrossRef]
- Dabbawala, A.A.; Ismail, I.; Vaithilingam, B.V.; Polychronopoulou, K.; Singaravel, G.; Morin, S.; Berthod, M.; Al Wahedi, Y. Synthesis of hierarchical porous Zeolite-Y for enhanced CO2 capture. Microporous Mesoporous Mater. 2020, 303, 110261. [Google Scholar] [CrossRef]
- Radoor, S.; Karayil, J.; Parameswaranpillai, J.; Siengchin, S. Adsorption Study of Anionic Dye, Eriochrome Black T from Aqueous Medium Using Polyvinyl Alcohol/Starch/ZSM-5 Zeolite Membrane. J. Polym. Environ. 2020, 28, 2631–2643. [Google Scholar] [CrossRef]
- Sabarish, R.; Jasila, K.; Aswathy, J.; Jyotishkumar, P.; Suchart, S. Fabrication of PVA/agar/modified ZSM-5 zeolite membrane for removal of anionic dye from aqueous solution. Int. J. Environ. Sci. Technol. 2020, 18, 2571–2586. [Google Scholar] [CrossRef]
- Radoor, S.; Karayil, J.; Jayakumar, A.; Nandi, D.; Parameswaranpillai, J.; Lee, J.; Shivanna, J.M.; Nithya, R.; Siengchin, S. Adsorption of Cationic Dye onto ZSM-5 Zeolite-Based Bio Membrane: Characterizations, Kinetics and Adsorption Isotherm. J. Polym. Environ. 2022, 30, 3279–3292. [Google Scholar] [CrossRef]
- Ismail, A.M.; Menazea, A.A.; Ali, H. Selective adsorption of cationic azo dyes onto zeolite nanorod-based membranes prepared via laser ablation. J. Mater. Sci. Mater. Electron. 2021, 32, 19352–19367. [Google Scholar] [CrossRef]
- Habiba, U.; Afifi, A.M.; Salleh, A.; Ang, B.C. Chitosan/(polyvinyl alcohol)/zeolite electrospun composite nanofibrous membrane for adsorption of Cr6+, Fe3+ and Ni2+. J. Hazard. Mater. 2017, 322, 182–194. [Google Scholar] [CrossRef] [PubMed]
- Baheri, B.; Ghahremani, R.; Peydayesh, M.; Shahverdi, M.; Mohammadi, T. Dye removal using 4A-zeolite/polyvinyl alcohol mixed matrix membrane adsorbents: Preparation, characterization, adsorption, kinetics, and thermodynamics. Res. Chem. Intermed. 2015, 42, 5309–5328. [Google Scholar] [CrossRef]
- Jin, X.; Jiang, M.-Q.; Shan, X.-Q.; Pei, Z.-G.; Chen, Z. Adsorption of methylene blue and orange II onto unmodified and surfactant-modified zeolite. J. Colloid Interface Sci. 2008, 328, 243–247. [Google Scholar] [CrossRef]
- Abukhadra, M.R.; Mohamed, A.S. Adsorption Removal of Safranin Dye Contaminants from Water Using Various Types of Natural Zeolite. Silicon 2018, 11, 1635–1647. [Google Scholar] [CrossRef]
- Hamd, A.; Dryaz, A.R.; Shaban, M.; AlMohamadi, H.; Abu Al-Ola, K.A.; Soliman, N.K.; Ahmed, S.A. Fabrication and Application of Zeolite/Acanthophora Spicifera Nanoporous Composite for Adsorption of Congo Red Dye from Wastewater. Nanomaterials 2021, 11, 2441. [Google Scholar] [CrossRef]
- Dryaz, A.R.; Shaban, M.; AlMohamadi, H.; Abu Al-Ola, K.A.; Hamd, A.; Soliman, N.K.; Ahmed, S.A. Design, characterization, and adsorption properties of Padina gymnospora/zeolite nanocomposite for Congo red dye removal from wastewater. Sci. Rep. 2021, 11, 21058. [Google Scholar] [CrossRef]
- Maroofi, S.M.; Mahmoodi, N.M. Zeolitic imidazolate framework-polyvinylpyrrolidone-polyethersulfone composites membranes: From synthesis to the detailed pollutant removal from wastewater using cross flow system. Colloids Surfaces A Physicochem. Eng. Asp. 2019, 572, 211–220. [Google Scholar] [CrossRef]
- Radoor, S.; Karayil, J.; Jayakumar, A.; Parameswaranpillai, J.; Siengchin, S. Release of toxic methylene blue from water by mesoporous silicalite-1: Characterization, kinetics and isotherm studies. Appl. Water Sci. 2021, 11, 110. [Google Scholar] [CrossRef]
- Yu, H.; Hong, H.-J.; Kim, S.M.; Ko, H.C.; Jeong, H.S. Mechanically enhanced graphene oxide/carboxymethyl cellulose nanofibril composite fiber as a scalable adsorbent for heavy metal removal. Carbohydr. Polym. 2020, 240, 116348. [Google Scholar] [CrossRef] [PubMed]
- Mittal, H.; Al Alili, A.; Morajkar, P.P.; Alhassan, S.M. GO crosslinked hydrogel nanocomposites of chitosan/carboxymethyl cellulose—A versatile adsorbent for the treatment of dyes contaminated wastewater. Int. J. Biol. Macromol. 2020, 167, 1248–1261. [Google Scholar] [CrossRef]
- Liu, C.; Omer, A.M.; Ouyang, X.-K. Adsorptive removal of cationic methylene blue dye using carboxymethyl cellulose/k-carrageenan/activated montmorillonite composite beads: Isotherm and kinetic studies. Int. J. Biol. Macromol. 2018, 106, 823–833. [Google Scholar] [CrossRef]
- Varaprasad, K.; Jayaramudu, T.; Sadiku, R. Removal of dye by carboxymethyl cellulose, acrylamide and graphene oxide via a free radical polymerization process. Carbohydr. Polym. 2017, 164, 186–194. [Google Scholar] [CrossRef]
- Moradi, O.; Mhdavi, S.; Sedaghat, S. Synthesis and characterization of chitosan/agar/SiO2 nano hydrogels for removal of amoxicillin and of naproxen from pharmaceutical contaminants. Res. Sq. 2021, 1–23. [Google Scholar]
- Sabarish, R.; Unnikrishnan, G. A novel anionic surfactant as template for the development of hierarchical ZSM-5 zeolite and its catalytic performance. J. Porous Mater. 2020, 27, 691–700. [Google Scholar] [CrossRef]
- Sabarish, R.; Unnikrishnan, G. Synthesis, characterization and catalytic activity of hierarchical ZSM-5 templated by carboxymethyl cellulose. Powder Technol. 2017, 320, 412–419. [Google Scholar] [CrossRef]
- Ekici, S.; Işıkver, Y.; Saraydın, D. Poly(Acrylamide-Sepiolite) Composite Hydrogels: Preparation, Swelling and Dye Adsorption Properties. Polym. Bull. 2006, 57, 231–241. [Google Scholar] [CrossRef]
- Darbasizadeh, B.; Fatahi, Y.; Feyzi-barnaji, B.; Arabi, M.; Motasadizadeh, H.; Farhadnejad, H.; Moraffah, F.; Rabiee, N. Crosslinked-polyvinyl alcohol-carboxymethyl cellulose/ZnO nanocomposite fibrous mats containing erythromycin (PVA-CMC/ZnO-EM): Fabrication, characterization and in-vitro release and anti-bacterial properties. Int. J. Biol. Macromol. 2019, 141, 1137–1146. [Google Scholar] [CrossRef] [PubMed]
- Lavanya, C.; Soontarapa, K.; Jyothi, M.S.; Geetha Balakrishna, R. Environmental friendly and cost effective caramel for congo red removal, high flux, and fouling resistance of polysulfone membranes. Sep. Purif. Technol. 2019, 211, 348–358. [Google Scholar] [CrossRef]
- Jesudoss, S.K.; Vijaya, J.J.; Kaviyarasu, K.; Kennedy, L.J.; Ramalingam, R.J.; Al-Lohedan, H.A. Anti-cancer activity of hierarchical ZSM-5 zeolites synthesized from rice-based waste materials. RSC Adv. 2017, 8, 481–490. [Google Scholar] [CrossRef]
- Gupta, S.; Pramanik, A.K.; Kailath, A.; Mishra, T.; Guha, A.; Nayar, S.; Sinha, A. Composition dependent structural modulations in transparent poly(vinyl alcohol) hydrogels. Colloids Surf. B Biointerfaces 2009, 74, 186–190. [Google Scholar] [CrossRef] [PubMed]
- Narayanan, S.; Vijaya, J.J.; Sivasanker, S.; Yang, S.; Kennedy, L.J. Hierarchical ZSM-5 catalyst synthesized by a Triton X-100 assisted hydrothermal method. Chin. J. Catal. 2014, 35, 1892–1899. [Google Scholar] [CrossRef]
- Kittur, A.A.; Kariduraganavar, M.Y.; Toti, U.S.; Ramesh, K.; Aminabhavi, T.M. Pervaporation separation of water-isopropanol mixtures using ZSM-5 zeolite incorporated poly(vinyl alcohol) membranes. J. Appl. Polym. Sci. 2003, 90, 2441–2448. [Google Scholar] [CrossRef]
- Prasad, C.V.; Swamy, B.Y.; Sudhakar, H.; Sobharani, T.; Sudhakar, K.; Subha, M.C.S.; Rao, K.C. Preparation and characterization of 4A zeolite-filled mixed matrix membranes for pervaporation dehydration of isopropyl alcohol. J. Appl. Polym. Sci. 2011, 121, 1521–1529. [Google Scholar] [CrossRef]
- Zhao, Q.; Qian, J.; An, Q.; Gao, C.; Gui, Z.; Jin, H. Synthesis and characterization of soluble chitosan/sodium carboxymethyl cellulose polyelectrolyte complexes and the pervaporation dehydration of their homogeneous membranes. J. Membr. Sci. 2009, 333, 68–78. [Google Scholar] [CrossRef]
- Chen, Z.; Pan, K. Enhanced removal of Cr(VI) via in-situ synergistic reduction and fixation by polypyrrole/sugarcane bagasse composites. Chemosphere 2021, 272, 129606. [Google Scholar] [CrossRef]
- Zhu, Z.; Xiang, M.; Li, P.; Shan, L.; Zhang, P. Surfactant-modified three-dimensional layered double hydroxide for the removal of methyl orange and rhodamine B: Extended investigations in binary dye systems. J. Solid State Chem. 2020, 288, 121448. [Google Scholar] [CrossRef]
- Litefti, K.; Freire, M.S.; Stitou, M.; González-Álvarez, J. Adsorption of an anionic dye (Congo red) from aqueous solutions by pine bark. Sci. Rep. 2019, 9, 16530. [Google Scholar] [CrossRef] [PubMed]
- Acemioğlu, B. Adsorption of Congo red from aqueous solution onto calcium-rich fly ash. J. Colloid Interface Sci. 2004, 274, 371–379. [Google Scholar] [CrossRef] [PubMed]
- Teli, S.B.; Calle, M.; Li, N. Poly(vinyl alcohol)-H-ZSM-5 zeolite mixed matrix membranes for pervaporation separation of methanol–benzene mixture. J. Membr. Sci. 2011, 371, 171–178. [Google Scholar] [CrossRef]
- Prince, J.A.; Singh, G.; Rana, D.; Matsuura, T.; Anbharasi, V.; Shanmugasundaram, T.S. Preparation and characterization of highly hydrophobic poly(vinylidene fluoride)—Clay nanocomposite nanofiber membranes (PVDF–clay NNMs) for desalination using direct contact membrane distillation. J. Membr. Sci. 2012, 397–398, 80–86. [Google Scholar] [CrossRef]
- Madan, S.; Shaw, R.; Tiwari, S.; Tiwari, S.K. Adsorption dynamics of Congo red dye removal using ZnO functionalized high silica zeolitic particles. Appl. Surf. Sci. 2019, 487, 907–917. [Google Scholar] [CrossRef]
- El-Shamy, A.G. An efficient removal of methylene blue dye by adsorption onto carbon dot @ zinc peroxide embedded poly vinyl alcohol (PVA/CZnO2) nano-composite: A novel Reusable adsorbent. Polymer 2020, 202, 122565. [Google Scholar] [CrossRef]
- Alver, E.; Metin, A. Anionic dye removal from aqueous solutions using modified zeolite: Adsorption kinetics and isotherm studies. Chem. Eng. J. 2012, 200–202, 59–67. [Google Scholar] [CrossRef]
- Rida, K.; Bouraoui, S.; Hadnine, S. Adsorption of methylene blue from aqueous solution by kaolin and zeolite. Appl. Clay Sci. 2013, 83–84, 99–105. [Google Scholar] [CrossRef]
- Alorabi, A.Q.; Hassan, M.S.; Azizi, M. Fe3O4-CuO-activated carbon composite as an efficient adsorbent for bromophenol blue dye removal from aqueous solutions. Arab. J. Chem. 2020, 13, 8080–8091. [Google Scholar] [CrossRef]
- Chatterjee, S.; Lee, D.S.; Lee, M.W.; Woo, S.H. Congo red adsorption from aqueous solutions by using chitosan hydrogel beads impregnated with nonionic or anionic surfactant. Bioresour. Technol. 2009, 100, 3862–3868. [Google Scholar] [CrossRef]
- Jaseela, P.; Garvasis, J.; Joseph, A. Selective adsorption of methylene blue (MB) dye from aqueous mixture of MB and methyl orange (MO) using mesoporous titania (TiO2)—Poly vinyl alcohol (PVA) nanocomposite. J. Mol. Liq. 2019, 286, 110908. [Google Scholar] [CrossRef]
- Maleki, A.; Mohammad, M.; Emdadi, Z.; Asim, N.; Azizi, M.; Safaei, J. Adsorbent materials based on a geopolymer paste for dye removal from aqueous solutions. Arab. J. Chem. 2018, 13, 3017–3025. [Google Scholar] [CrossRef]
- Yan, C.; Cheng, Z.; Tian, Y.; Qiu, F.; Chang, H.; Li, S.; Cai, Y.; Quan, X. Adsorption of Ni(II) on detoxified chromite ore processing residue using citrus peel as reductive mediator: Adsorbent preparation, kinetics, isotherm, and thermodynamics analysis. J. Clean. Prod. 2021, 315, 128209. [Google Scholar] [CrossRef]
- Wu, K.-H.; Huang, W.-C.; Hung, W.-C.; Tsai, C.-W. Modified expanded graphite/Fe3O4 composite as an adsorbent of methylene blue: Adsorption kinetics and isotherms. Mater. Sci. Eng. B 2021, 266, 115068. [Google Scholar] [CrossRef]
- Bensalah, H.; Younssi, S.A.; Ouammou, M.; Gurlo, A.; Bekheet, M.F. Azo dye adsorption on an industrial waste-transformed hydroxyapatite adsorbent: Kinetics, isotherms, mechanism and regeneration studies. J. Environ. Chem. Eng. 2020, 8, 103807. [Google Scholar] [CrossRef]
- Hao, L.; Gao, W.; Yan, S.; Niu, M.; Liu, G.; Hao, H. Functionalized diatomite/oyster shell powder doped electrospun polyacrylonitrile submicron fiber as a high-efficiency adsorbent for removing methylene blue from aqueous solution: Thermodynamics, kinetics and isotherms. J. Mol. Liq. 2020, 298, 112022. [Google Scholar] [CrossRef]
- Chen, W.; Ma, H.; Xing, B. Electrospinning of multifunctional cellulose acetate membrane and its adsorption properties for ionic dyes. Int. J. Biol. Macromol. 2020, 158, 1342–1351. [Google Scholar] [CrossRef]
- Bo, L.; Gao, F.; Shuangbao; Bian, Y.; Liu, Z.; Dai, Y. A novel adsorbent Auricularia Auricular for the removal of methylene blue from aqueous solution: Isotherm and kinetics studies. Environ. Technol. Innov. 2021, 23, 101576. [Google Scholar] [CrossRef]
- Vimonses, V.; Lei, S.; Jin, B.; Chow, C.W.K.; Saint, C. Kinetic study and equilibrium isotherm analysis of Congo Red adsorption by clay materials. Chem. Eng. J. 2009, 148, 354–364. [Google Scholar] [CrossRef]
- Wekoye, J.N.; Wanyonyi, W.C.; Wangila, P.T.; Tonui, M.K. Kinetic and equilibrium studies of Congo red dye adsorption on cabbage waste powder. Environ. Chem. Ecotoxicol. 2020, 2, 24–31. [Google Scholar] [CrossRef]
- Wanyonyi, W.C.; Onyari, J.M.; Shiundu, P.M. Adsorption of Congo Red Dye from Aqueous Solutions Using Roots of Eichhornia Crassipes: Kinetic and Equilibrium Studies. Energy Procedia 2014, 50, 862–869. [Google Scholar] [CrossRef]
- Tor, A.; Cengeloglu, Y. Removal of congo red from aqueous solution by adsorption onto acid activated red mud. J. Hazard. Mater. 2006, 138, 409–415. [Google Scholar] [CrossRef] [PubMed]
- Vimonses, V.; Lei, S.; Jin, B.; Chow, C.W.; Saint, C.; Chow, C.; Saint, C. Adsorption of congo red by three Australian kaolins. Appl. Clay Sci. 2009, 43, 465–472. [Google Scholar] [CrossRef]
- Mall, I.D.; Srivastava, V.C.; Agarwal, N.K.; Mishra, I.M. Removal of congo red from aqueous solution by bagasse fly ash and activated carbon: Kinetic study and equilibrium isotherm analyses. Chemosphere 2005, 61, 492–501. [Google Scholar] [CrossRef] [PubMed]
- Chowdhury, A.K.; Sarkar, A.D.; Bandyopadhyay, A. Rice Husk Ash as a Low Cost Adsorbent for the Removal of Methylene Blue and Congo Red in Aqueous Phases. CLEAN—Soil Air Water 2009, 37, 581–591. [Google Scholar] [CrossRef]
- Reddy, M. Removal of Direct Dye from Aqueous Solutions with an Adsorbent Made from Tamarind Fruit Shell, an Agricultural Solid Waste. J. Sci. Ind. Res. 2006, 65, 443–446. [Google Scholar]
- Meshram, E.; Meshram, S. Evaluation of adsorptive capacity of bioadsorbent in removal of Congo Red from aqueous solution, Inst. J. Res. Sci. 2015, 4, 2217–2221. [Google Scholar]

| Name | MW (g/moL) | Group | λmax (nm) | Structure |
|---|---|---|---|---|
| Congo red (CR) | 696.66 | -SO3- -NH2 -N = N- | 492 | ![]() |
| Samples | PVA (wt%) | CMC (wt%) | AGAR (wt%) | ZSM-5 Zeolite (wt%) |
|---|---|---|---|---|
| AG-0 | 10 | 1 | 4 | 0 |
| AG-1 | 10 | 1 | 4 | 2 |
| AG-2 | 10 | 1 | 4 | 4 |
| AG-3 | 10 | 1 | 4 | 6 |
| Samples Code | Weight Loss of Biomembrane at Different Temperature | Total Weight Loss (%) | ||
|---|---|---|---|---|
| 30–170 °C | 180–370 °C | 380–650 °C | ||
| ZSM-5 | 9.13 | 19.56 | 6.26 | 34.95 |
| AG-0 | 13.43 | 38.07 | 34.86 | 86.36 |
| AG-1 | 10.21 | 34.61 | 30.98 | 75.80 |
| AG-2 | 10.65 | 32.14 | 29.01 | 71.80 |
| AG-3 | 6.82 | 32.05 | 29.41 | 68.28 |
| Samples Code | Tensile Strength (MPa) | Elongation at Break (%) |
|---|---|---|
| AG-0 | 35.87 ± 3.35 | 69.72 ± 3.71 |
| AG-1 | 31.75 ± 2.40 | 30.66 ± 5.24 |
| AG-2 | 29.41 ± 5.04 | 25.71 ± 3.28 |
| AG-3 | 23.29 ± 0.46 | 19.37 ± 4.97 |
| ΔG(kj/moL) | ΔH(kj/moL) | ΔS (j/moL K) | ||
|---|---|---|---|---|
| 303 K | 313 K | 323 K | ||
| −9.129 | −3.16 | −0.49 | −83.6 | −257 |
| Kinetic Models | |
|---|---|
| PFO | |
| qe (mg g−1) | 3.7 |
| KL/min | 0.0376 |
| R2 | 99 |
| PSO | |
| qe (mg g−1) | 18.2 |
| R2 | 99.2 |
| K2 (g mg−1 min−1) | 2.38 × 10−3 |
| IPD | |
| C (mg g−1) | −1.14 |
| R2 | 95 |
| Kid (g mg−1 min1/2) | 1.65 |
| Isotherm Models | ||
|---|---|---|
| Model | Parameters | |
| Langmuir | qm (mg g−1) | 73 |
| KL (L mg−1) | 0.248 | |
| R2 | 98 | |
| Freundlich | KF (mg g −1) | 16.8 |
| R2 | 98 | |
| n | 0.436 | |
| Adsorbents | qe (mg/g) | References |
|---|---|---|
| Coir pith carbon | 6.7 | [76] |
| Kaolin | 5.6 | [79] |
| Zeolite | 4.3 | [79] |
| Cabbage waste powder | 1.78 | [80] |
| Roots of Eichhornia crassipes | 4.81 | [81] |
| Red mud | 4.05 | [82] |
| Australian kaolins | 5.58 | [83] |
| Bagasse fly ash | 11.88 | [84] |
| Rice husk ash | 7.047 | [85] |
| Tamarind fruit shell | 10.5 | [86] |
| Nilgiri bark | 12.4 | [87] |
| Agar/zeolite/CMC/PVA | 15.30 | This work |
| ZSM-5 zeolite | 6.4 | This work |
Publisher’s Note: MDPI stays neutral with regard to jurisdictional claims in published maps and institutional affiliations. |
© 2022 by the authors. Licensee MDPI, Basel, Switzerland. This article is an open access article distributed under the terms and conditions of the Creative Commons Attribution (CC BY) license (https://creativecommons.org/licenses/by/4.0/).
Share and Cite
Radoor, S.; Karayil, J.; Jayakumar, A.; Lee, J.; Nandi, D.; Parameswaranpillai, J.; Pant, B.; Siengchin, S. Efficient Removal of Organic Dye from Aqueous Solution Using Hierarchical Zeolite-Based Biomembrane: Isotherm, Kinetics, Thermodynamics and Recycling Studies. Catalysts 2022, 12, 886. https://doi.org/10.3390/catal12080886
Radoor S, Karayil J, Jayakumar A, Lee J, Nandi D, Parameswaranpillai J, Pant B, Siengchin S. Efficient Removal of Organic Dye from Aqueous Solution Using Hierarchical Zeolite-Based Biomembrane: Isotherm, Kinetics, Thermodynamics and Recycling Studies. Catalysts. 2022; 12(8):886. https://doi.org/10.3390/catal12080886
Chicago/Turabian StyleRadoor, Sabarish, Jasila Karayil, Aswathy Jayakumar, Jaewoo Lee, Debabrata Nandi, Jyotishkumar Parameswaranpillai, Bishweshwar Pant, and Suchart Siengchin. 2022. "Efficient Removal of Organic Dye from Aqueous Solution Using Hierarchical Zeolite-Based Biomembrane: Isotherm, Kinetics, Thermodynamics and Recycling Studies" Catalysts 12, no. 8: 886. https://doi.org/10.3390/catal12080886
APA StyleRadoor, S., Karayil, J., Jayakumar, A., Lee, J., Nandi, D., Parameswaranpillai, J., Pant, B., & Siengchin, S. (2022). Efficient Removal of Organic Dye from Aqueous Solution Using Hierarchical Zeolite-Based Biomembrane: Isotherm, Kinetics, Thermodynamics and Recycling Studies. Catalysts, 12(8), 886. https://doi.org/10.3390/catal12080886


